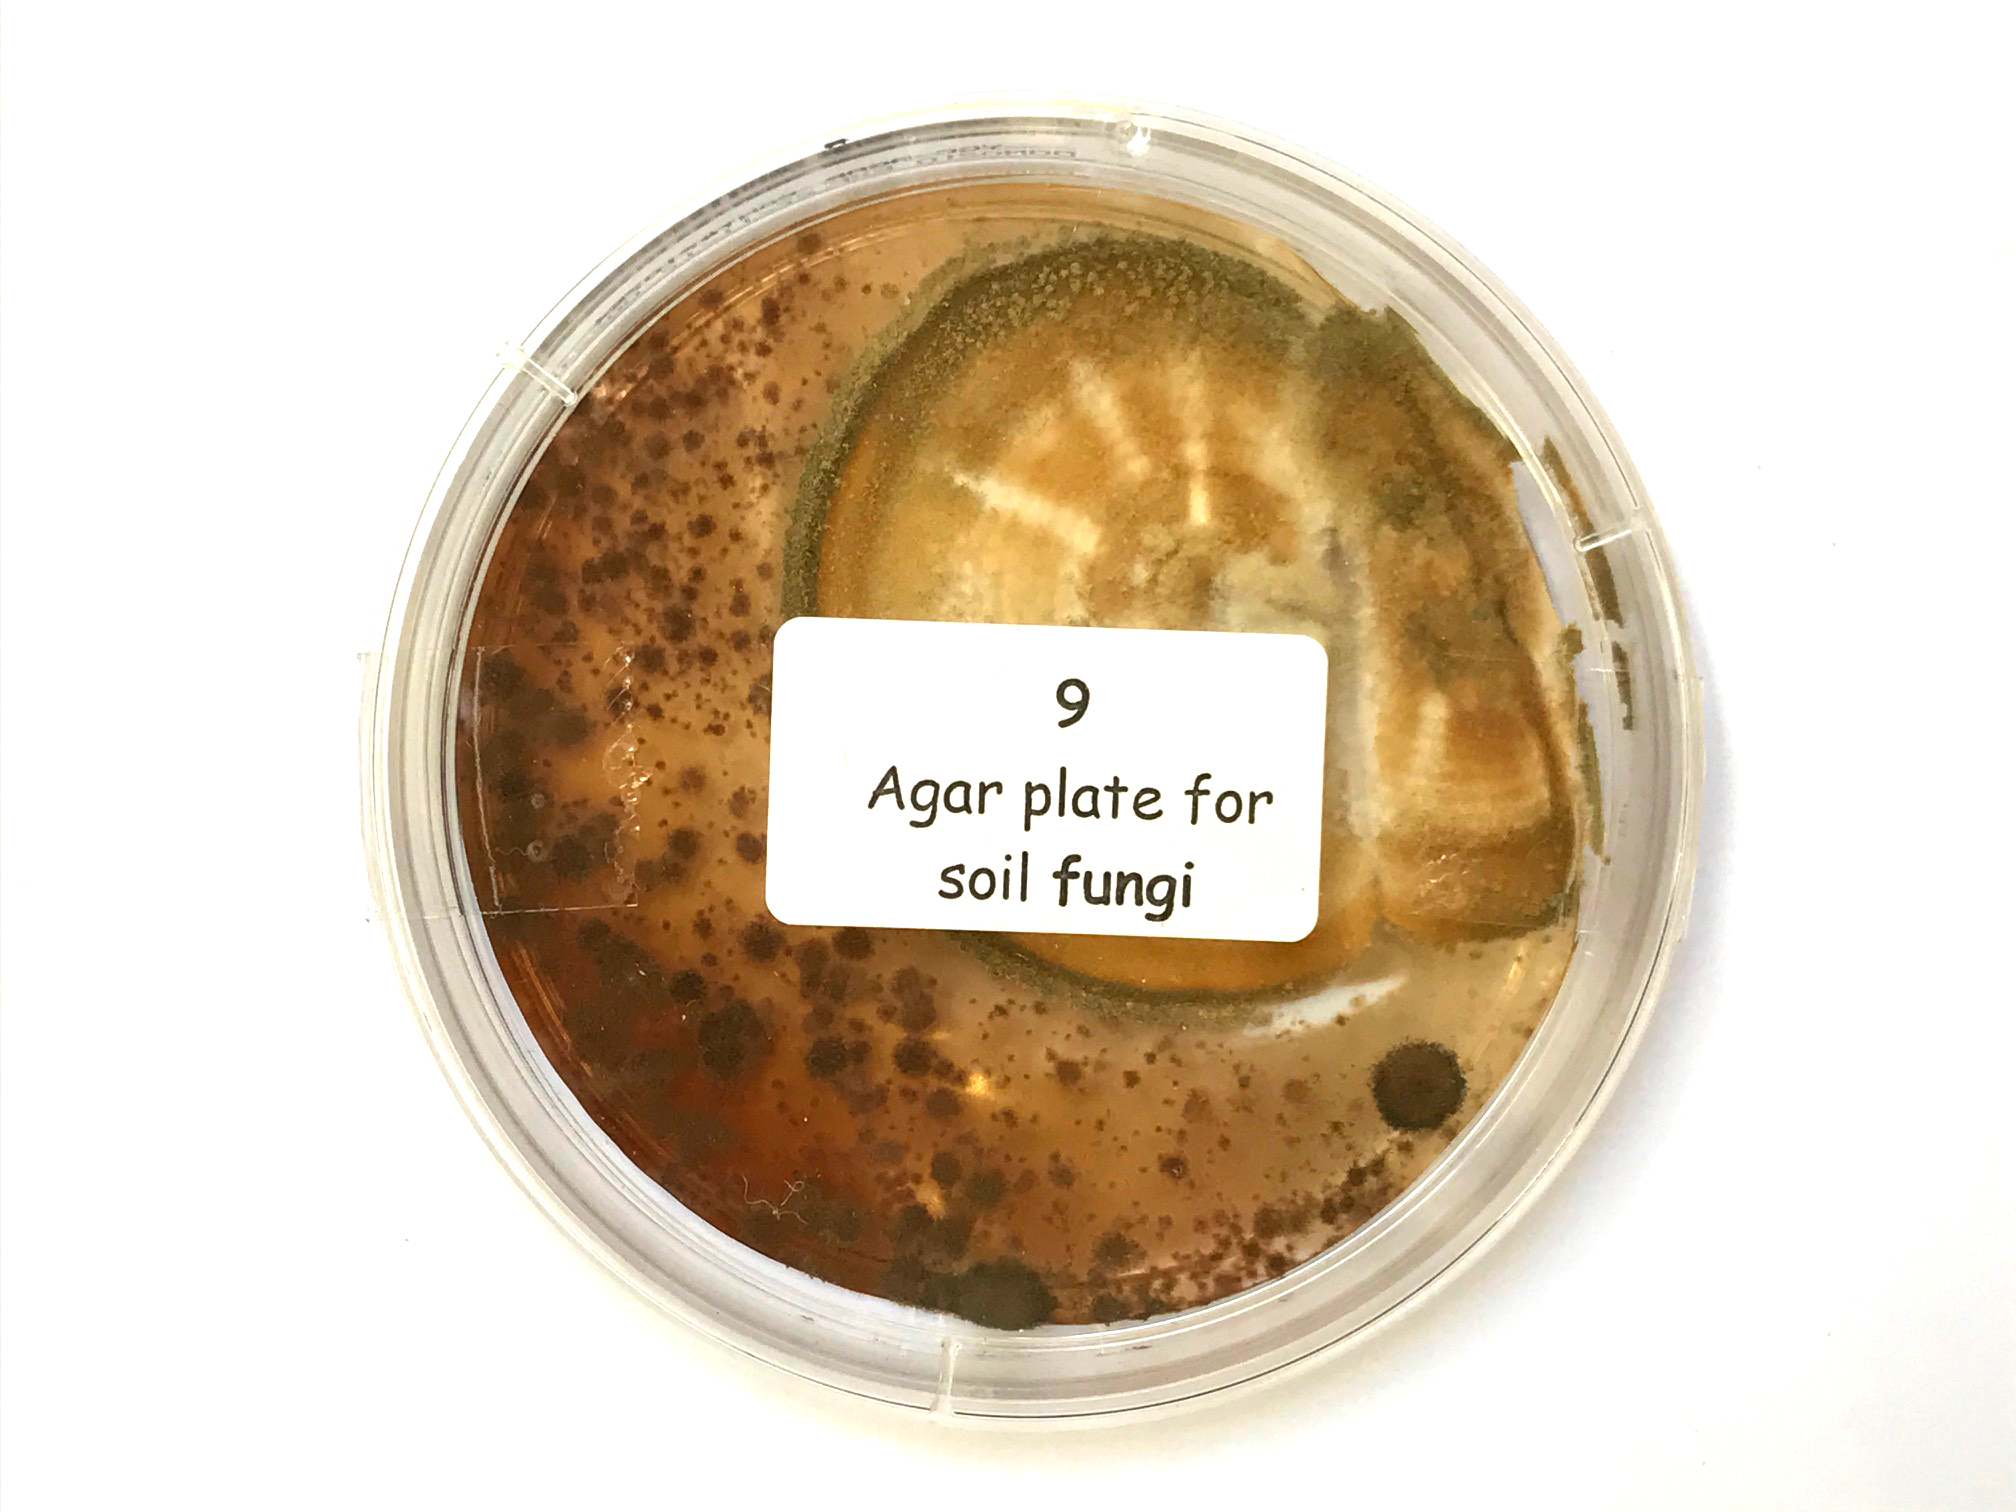
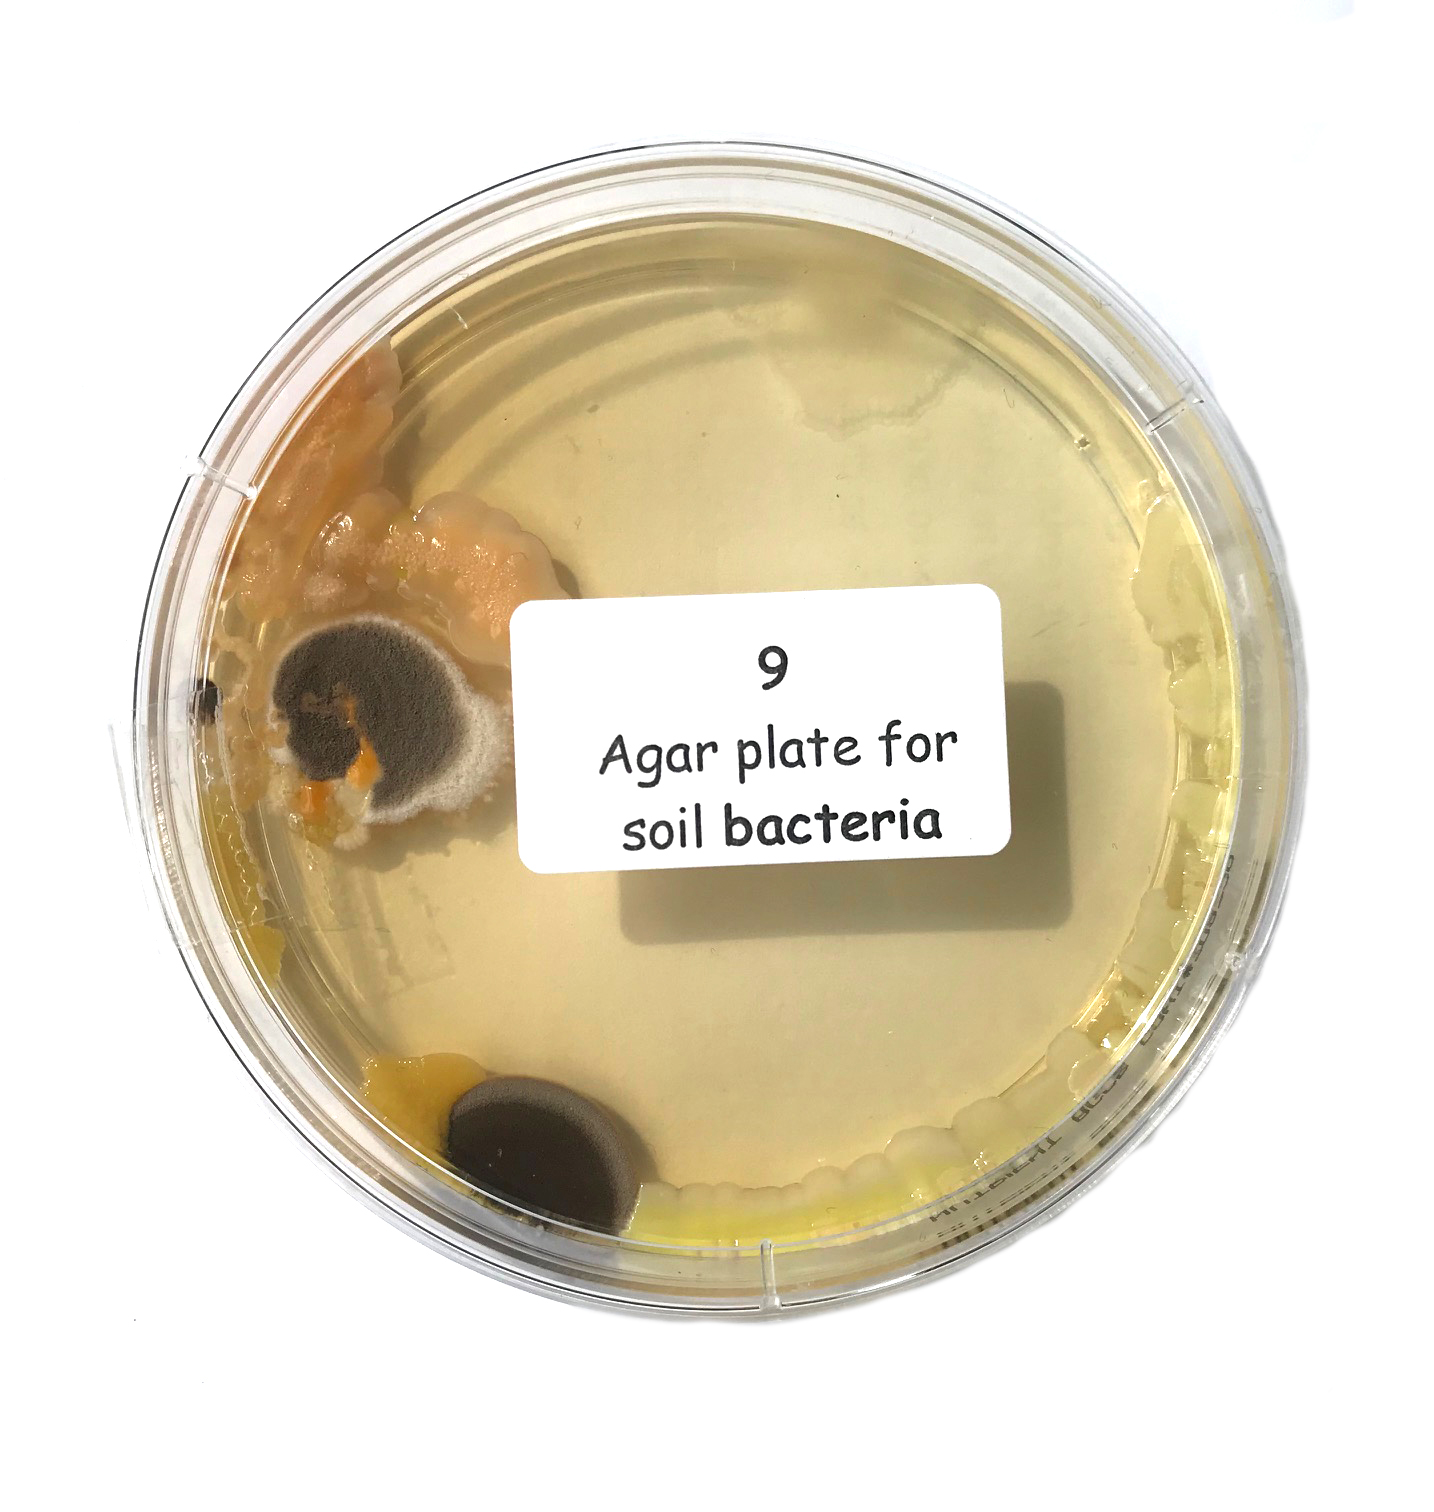

The good bacteria and fungi in the soil
As well as the tiny insects and other animals which break down dead plant material to provide nutrients, beneficial fungi and bacteria are absolutely vital to good soil. Many gardening and farming practices reduce the numbers of these organisms (by digging, ploughing, spraying chemicals, compaction, water logging etc.), so this technique gives us an idea of how healthy the populations are in your soil.
Using the agar plates
You are provided with two plastic dishes, each containing a seaweed gel called agar to which particular nutrients have been added. One dish has been prepared to illustrate beneficial fungal growth on its surface, while the other is selective for good bacteria.
Take a level teaspoonful of your soil and shake it well in a jam-jar-sized container with 100 ml of tap water. Leave for 5 minutes to let the soil settle.
Dip the bottom of a matchstick into the water above the soil layer and place one drop of the water on to the agar in the middle of each plastic dish. Replace the lid and keep the dishes at room temperature out of the sun.
Check the dishes each day until obvious growth has occurred on both and examine what has appeared. If you have access to a binocular microscope, take a closer look or, more simply, use the magnifying glass provided. We cannot name the organisms growing in the dishes, but their appearance gives some idea of the hidden biodiversity living in the soil

Project 1
If the growth in one or more of the dishes is prolific, it suggests you have been looking after your soil well, meaning that it has a good structure and is high in organic matter. If very little grows, the best solution is to dig in some organic matter such as home-made or bought compost, kitchen waste or simply mulch the soil with pea straw. The latter decays very rapidly and when you rake it in a few months’ time you will see that the soil has a dark, peaty layer where the straw was. This must be good!
Project 2
You can check up to four sites per plate by placing a drop of water from each site into each quadrant.
How Does Your Garden Grow Kit
This unique kit is based on research carried out in the Bio-Protection Research Centre at Lincoln University in association with the BHU Organics Trust and Kings Seeds. The kit will help you to discover a number of important things such as the acidity of your soil (slightly acid for potatoes, slightly alkaline for brassicas) and how to attract bees to your crops and ladybirds to eat your pests.